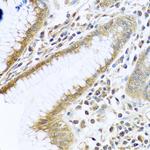
TMEM189 Antibody in Immunohistochemistry (Paraffin) (IHC (P))

Search
Invitrogen
TMEM189 Polyclonal Antibody
{{$productOrderCtrl.translations['antibody.pdp.commerceCard.promotion.promotions']}}
{{$productOrderCtrl.translations['antibody.pdp.commerceCard.promotion.viewpromo']}}
{{$productOrderCtrl.translations['antibody.pdp.commerceCard.promotion.promocode']}}: {{promo.promoCode}} {{promo.promoTitle}} {{promo.promoDescription}}. {{$productOrderCtrl.translations['antibody.pdp.commerceCard.promotion.learnmore']}}
图: 1 / 3
TMEM189 Antibody (PA5-97031) in IHC (P)

Please note: We are reviewing Western blot images included in the antibody testing data in our catalog, including those provided by third parties. Unless expressly labeled or annotated as “raw-unedited”, Western blot images included in the antibody testing data in our catalog may have been edited, optimized or otherwise adjusted for presentation.
产品信息
PA5-97031
种属反应
宿主/亚型
分类
类型
抗原
偶联物
形式
浓度
规格
纯化类型
保存液
内含物
保存条件
运输条件
RRID
产品详细信息
Positive Samples: MCF7; Cellular Location: Endoplasmic reticulum membrane, Multi-pass membrane protein
Immunogen sequence: FVFCLIIFGT FTNQIHKWSH TYFGLPRWVT LLQDWHVILP RKHHRIHHVS PHETYFCITT GWLNYPLEKI GFWRRLEDLI QGLTGEKPRA DDMKWAQKIK
靶标信息
Ubiquitin-conjugating E2 enzyme variant proteins constitute a distinct subfamily within the E2 protein family. They have sequence similarity to other ubiquitin-conjugating enzymes but lack the conserved cysteine residue that is critical for the catalytic activity of E2s. The protein encoded by this gene is located in the nucleus and can cause transcriptional activation of the human FOS proto-oncogene. It is thought to be involved in the control of differentiation by altering cell cycle behavior. Multiple alternatively spliced transcripts encoding different isoforms have been described for this gene. A pseudogene has been identified which is also located on chromosome 20. Co-transcription of this gene and the neighboring upstream gene generates a rare transcript (Kua-UEV), which encodes a fusion protein comprised of sequence sharing identity with each individual gene product.
仅用于科研。不用于诊断过程。未经明确授权不得转售。




